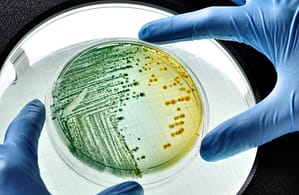
Infecciones Urinarias Complicadas

Infecciones Urinarias Complicadas
Durante muchos años persistió la controversia respecto de la incidencia aumentada de IU en pacientes diabéticos. Varios estudios recientes (1-3) parecen haber demostrado, en diseños de casos y controles, que la diabetes, independientemente de otros factores triplica el riesgo de bacteriuria asintomática y de IU (Infecciones Urinarias).
Fuente: Consenso Argentino Intersociedades para el Manejo de la Infección del Tracto Urinario – Parte III Intersociety Argentinean Consens usf or Management of the Urinary Tract Infection – Part III
Sociedades Participantes:
Sociedad Argentina de Infectología (SADI),Sociedad Argentina de Urología (SAU),Sociedad Argentina de Medicina (SAM),Sociedad Argentina de Bacteriología Clínica (SADEBAC),Sociedad de Ginecología y Obstetricia de Buenos Aires (SOGIBA).
Autores del Consenso:
Coordinador: Gabriel Levy Hara1 (SADI)
Secretario: Gustavo Lopardo2 (SADI)
SADI: María José López Furst3, Liliana Clara4, Daniel Pryluka5, Javier Desse6, Liliana Vázquez7,Gabriela Saravia8, Joaquín Bermejo9, Jorge
Gentile10, Sergio Prieto11, Beatriz Ricci12 y Alicia Lizzi13.
SAU: Daniel Varcasia14, José Simhan15, Luis Lisenfeld16 y Daniel Ekizian17.
SADEBAC: Horacio Lopardo18, Jorgelina
Smayevsky19, Federico Nicola20 y Sara Kaufman21.
SAM: Manuel Klein22, Claudio Baldomir23 y Gustavo Badariotti24.
SOGIBA: Francisco Basilio25, Juan Carlos Nassif26 y César Ponce27.
1 Infectólogo, Servicio de Infectología, Hospital Durand, Buenos Aires, Argentina.
2 Infectólogo, Servicio de Infectología, Hospital Bernardo Houssay, Vicente López (Pcia. de Buenos Aires), Argentina.
3 Infectóloga, Servicio de Infectología, Sanatorio Méndez, Buenos Aires, Argentina.
4 Infectóloga, Servicio de Infectología, Hospital Italiano, Buenos Aires, Argentina.
5 Infectólogo, Servicio de Infectología, Hospital Vélez Sársfield,Buenos Aires, Argentina.
6 Infectólogo, Servicio de Infectología, Hospital HIGA Diego Paroissien, Isidro Casanova (Pcia. de Buenos Aires), Argentina.
7 Infectóloga, Fundación Centro de Estudios Infectológicos,Buenos Aires, Argentina.
8 Médica Clínica, Hospital Italiano, Buenos Aires, Argentina.
9 Infectólogo, Unidad de Enfermedades Infecciosas, Hospital Español, Rosario (Pcia. de Santa Fe), Argentina.
10Infectólogo, Servicio de Infectología, Hospital Ramón Santamarina, Tandil (Pcia. de Buenos Aires), Argentina.
11Infectólogo, Servicio de Infectología, Hospital Carlos Bocalandro, LomaHermosa (Pcia. de Buenos Aires), Argentina.
12Infectóloga, Servicio de Infectología, Instituto de Rehabilitación Psicofísica, Buenos Aires, Argentina.
13Enfermera en Control de Infecciones, Servicio de Infectología, Hospital Italiano, Buenos Aires, Argentina.
14Urólogo, Unidad de Urología, Hospital Aeronáutico Central, Buenos Aires, Argentina.
15Urólogo, Unidad de Urología, Hospital Aeronáutico Central, Buenos Aires, Argentina.
16Urólogo, Unidad de Urología, Hospital Aeronáutico Central, Buenos Aires, Argentina.
17Urólogo, Unidad de Urología, Hospital Israelita, Buenos Aires, Argentina.
18Microbiólogo, Servicio de Microbiología, Hospital de Pediatría “Prof. Dr. Juan P. Garrahan”, Buenos Aires, Argentina.
19Bioquímica, Especialista en Microbiología Clínica, Laboratorio de Microbiología, CEMIC, Buenos Aires, Argentina.
20Microbiólogo, Laboratorios Britania, Buenos Aires, Argentina.
21Microbióloga, Sección Microbiología, Hospital Fernández, Buenos Aires, Argentina.
22Médico Clínico, Unidad de Clínica Médica, Clínica Modelo de Lanús, Buenos Aires, Argentina.
23Médico Clínico, Departamento de Medicina Interna, Policlínico Bancario, Buenos Aires, Argentina.
24Médico Clínico, Unidad de Cuidados Especiales, Sanatorio Mater Dei, Buenos Aires, Argentina.
25Tocoginecólogo, Unidad de Tocoginecología, Hospital Durand,BuenosAires, Argentina.
26Tocoginecólogo, Unidad de Tocoginecología,Hospital Durand, Buenos Aires, Argentina.
27Tocoginecólogo, Unidad de Tocoginecología, Hospital Durand, Buenos Aires, Argentina.
Correspondencia:
Dr. Gabriel Levy Hara
Av. Díaz Vélez 5044, 1406 Buenos Aires, Argentina.
e-mail: glevyhara@fibertel.com.ar
En esta tercera parte del Consenso Argentino Intersociedades para el Manejo de la Infección del Tracto Urinario desarrollaremos la segunda sección referente a las IU complicadas. La misma abarca las IU en pacientes diabéticos, en sondados, en pacientes con stents ureterales o catéteres doble J y manejo de la bacteriuria asintomática.
INFECCIÓN URINARIA EN PACIENTES DIABÉTICOS
Presentación del problema
Durante muchos años persistió la controversia respecto de la incidencia aumentada de IU en pacientes diabéticos. Varios estudios recientes (1-3) parecen haber demostrado, en diseños de casos y controles, que la diabetes, independientemente de otros factores triplica el riesgo de bacteriuria asintomática y de IU (Infecciones Urinarias).
Este aumento no tendría relación con la forma clínica de la diabetes, la presencia de compromiso vascular o neuropático, el grado de residuo post-miccional o el nivel de control de la glucemia a corto o largo plazo. Los factores de riesgo para el desarrollo de IU en mujeres con diabetes no están bien definidos, y si bien la presencia de bacteriuria asintomática parece incrementar la posibilidad de un desarrollo posterior de IU, la búsqueda sistemática de esta condición no está recomendada (4).
Sin embargo, es importante establecer que, dada la elevada tasa de bacteriuria asintomática y la frecuencia de otras causas de fiebre en estos pacientes, el solo hecho de que un paciente diabético presente fiebre más bacteriuria no debe interpretarse como una IU. Por el contrario, es preciso descartar antes otros focos probables de infección.
Fisiopatogenia y características particulares de la asociación entre infección urinaria y diabetes
Las observaciones clínicas recientes han arrojado luz sobre el mecanismo patogénico de las IU en pacientes diabéticos. El desarrollo del cuadro clínico en las mujeres es precedido por la colonización del epitelio vaginal y del periné por parte del agente causal (habitualmente bacilos gram negativos) que desde allí ascienden a la vejiga. Las características intrínsecas de la colonización del epitelio urinario fue ampliamente estudiada para E. coli, cuyas adhesinas (fimbrias tipo 1, P y S y otras adhesinas) se fijan a moléculas específicas del uroepitelio tales como glucoesfingolipidos y uroplakinas (5).
La diabetes ha demostrado prolongar el tiempo de hospitalización de los casos de IU e incrementar las tasas de internación por pielonefritis, pero no parece modificar la mortalidad directamente relacionada (6). Sin embargo, se ha observado que los pacientes con pielonefritis aguda tienen un peor pronóstico (7).
La bacteriuria asintomática ha demostrado ser un factor relacionado a la ocurrencia de IU especialmente en diabetes tipo I (2). Sin embargo, no hay evidencia que indique que esta bacteriuria pueda prevenirse ni modificarse favorablemente con el tratamiento y por lo tanto, no está indicado su rastreo en diabéticos (8).
Los pacientes diabéticos pueden presentar más frecuentemente síntomas urinarios, deterioro del sensorio, historia de incontinencia relacionada con los episodios de IU, e infecciones urinarias por otros patógenos además de E. coli (9).
En efecto, las IU por K. pneumoniae, Streptococcus agalactiae y C. albicans son más frecuentes en esta población (10).
Por su parte, la diabetes parecería asociarse, de acuerdo con series de casos publicadas, a formas más severas de presentación clínica de la IU como pielonefritis enfisematosa, necrosis papilar renal, pielonefritis xantogranulomatosa y abscesos renales y perirrenales, aunque su incidencia relativa no está definida especialmente para las formas más infrecuentes. La pielonefritis enfisematosa es una infección necrotizante que compromete al parénquima renal y al tejido perirrenal (11). Más del 90% de los casos ocurren en diabéticos (12). Otras complicaciones observadas en estos pacientes son la cistitis enfisematosa y la pielitis enfisematosa.
Tratamiento
En el paciente diabético, la IU debe considerarse complicada dada la mayor probabilidad de alteraciones subyacentes de las vías urinarias (anatómicas y funcionales), y de complicaciones locales y sistémicas. Por lo tanto a todo paciente con esta condición se le debe realizar urocultivo y una evaluación clínica completa para determinar la presencia de descompensación metabólica y/o síndrome de respuesta inflamatoria sistémica (SIRS), ya que éstos constituyen criterios de internación y de realización de hemocultivos.
El tratamiento empírico inicial para aquellos casos que no requieren internación así como para aquellos que no tienen antecedentes de antibioticoterapia previa de amplio espectro o instrumentación urológica reciente (definida como aquella que no fue realizada dentro de los 30 días) puede iniciarse con una fluoroquinolona por vía oral (como la ciprofloxacina), o en su defecto con aminopenicilinas + inhibidor de beta-lactamasa.
Por su parte, en casos de pacientes que poseen un cateterismo urinario crónico, o múltiples tratamientos previos resulta difícil establecer una recomendación general pero parece prudente indicar un aminoglucósido (en particular, amicacina 1 g/día), una cefalosporina de 3 o 4 generación, un betalactámico antipseudomonadal + inhibidor de betalactamasa, o un carbapenem. Como fue señalado en varios apartados del presente Consenso Intersociedades para los casos de otras situaciones que ocurren en pacientes con antecedentes similares de procedimientos invasivos y/o ATB previos, la decisión de cuál de estas opciones terapéuticas utilizar se deberá individualizar en función de la historia personal de cada paciente.
La duración del tratamiento antibiótico para la pielonefritis aguda debe ser de 10 a 14 días.
El paciente debe ser seguido en forma estrecha frente a la posibilidad de una mala evolución precoz.
Todo paciente hospitalizado como consecuencia de la severidad de la presentación inicial debe evaluarse dentro de las 72 hs de iniciado el
tratamiento para definir la necesidad de realizar un estudio por imágenes (ecografía o TAC) que permita descartar alguna de las formas clínicas más severa arriba descriptas o una complicación supurada que requiera resolución quirúrgica.
La indicación del estudio urológico luego de superado el evento agudo es controvertida. El mismo estaría justificado para los casos que no tienen alteraciones conocidas de las vías urinarias previas y han requerido internación.
Prevención de las infecciones urinarias en diabéticos y de sus complicaciones
En la Tabla 1 se describen algunas de las medidas propuestas para prevenir la aparición de IU y sus complicaciones en esta población (13).
| Tabla 1Recomendaciones para la prevención de la infección urinaria en diabéticos y sus complicaciones |
| *Mantener un buen control metabólico (HbA1c*Limitar el uso de catéteres uriarios*Profilaxis antibiótica para prevenir infecciones en mujeres sexualmente activas que tengan dos o más episodios al año relacionados al acto sexual.*Mantener un perfil de “euglucemia” en situaciones tales como cirugías u otros procedimientos asociados a stress |
1. Nicolle EL. Urinary tract infection in diabetes. Current Opinion Inf Dis 2005;18:49-53.
2. Muller LM, Hoepelman A. Increased risk of common infections in patients with type 1 and type 2 diabetes mellitus. CID 2005;41:281-8.
3. Geerling Suzanne E. Risk factors for syntomatic urinary tract infection in women with diabetes. Diabetes Care 2000;23:1737-1741.
4. Brown JS, Wessells H, Chancellor MB, Howards SS, Stamm WE, Stapleton AE et al. Urologic complications of diabetes. Diabetes Care 2005;28:177-85.
5. Johnson JR. Microbial virulence determinants and the patogénesis of urinary tract infection. Infect Dis Clin North Am 2003;17:261-278.
6. Boyko EJ, Fihn SD, Scholes D, Chen CL, Normand EH, Yarbro P. Diabetes and the risk of acute urinary tract infection among postmenopausal women. Diabetes Care 2002;25:1778-1783.
7. Efstathiou SP, Pefanis AV, Tsioulos DI, Zacharos ID, Tsiakou AG, Mitromaras AG. Acute pyelonephritis in adults: prediction of mortality and failure of treatment. Arch Intern Med 2003;163:1206-1212.
8. Stapleton A. Urinary tract infections in patients with diabetes. Am J Med 2002;113 (Suppl 1A):80S-84S.
9. Horcajada JP, Morenal L. Community acquired fibrile urinary tract infection in diabetes could deserve a different managment: a case control study. J Inter Med 2003;254:280-286.
10. Hoepelman AI, Meiland R, Geerlings SE. Pathogenesis and management of bacterial urinary tract infections in adult patients with diabetes mellitus. Int J Antimicrob Agents 2003;22(Suppl2):35-43.
11. Kumar A, Turney JH, Brownjohn AM, McMahon MJ. Unusual bacterial infections of the urinary tract in diabetic patients – rare but frequently lethal. Nephrol Dial Transplant 2001;16:1062-5.
12. Evanoff GV, Thompson CS, Foley R, Weinman EJ. Spectrum of gas within the kidney. Emphysematous pyelonephritis and emphysematous pyelitis. Am J Med 1987;83:149-154.
13. Ronald A, Ludwing E. Urinary tract infections in adults with diabetes. International.J of Antimicrob Agents 2001;17:287-292





